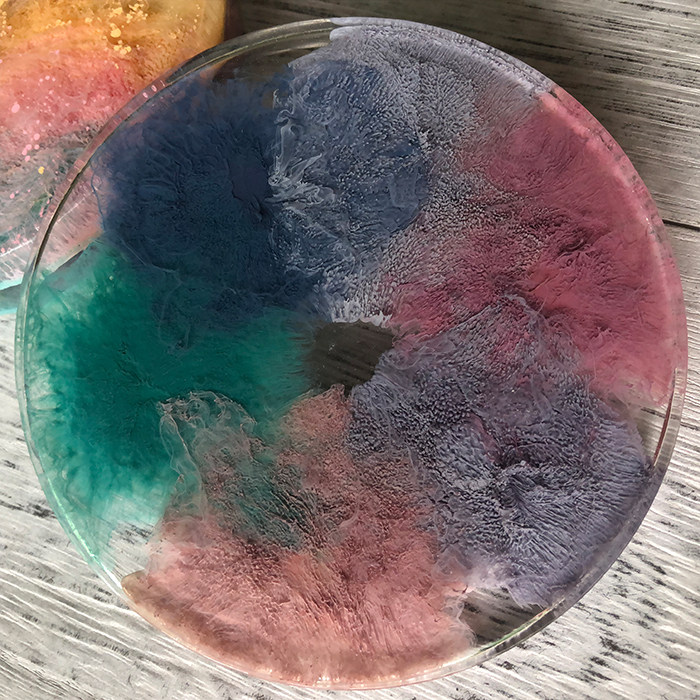
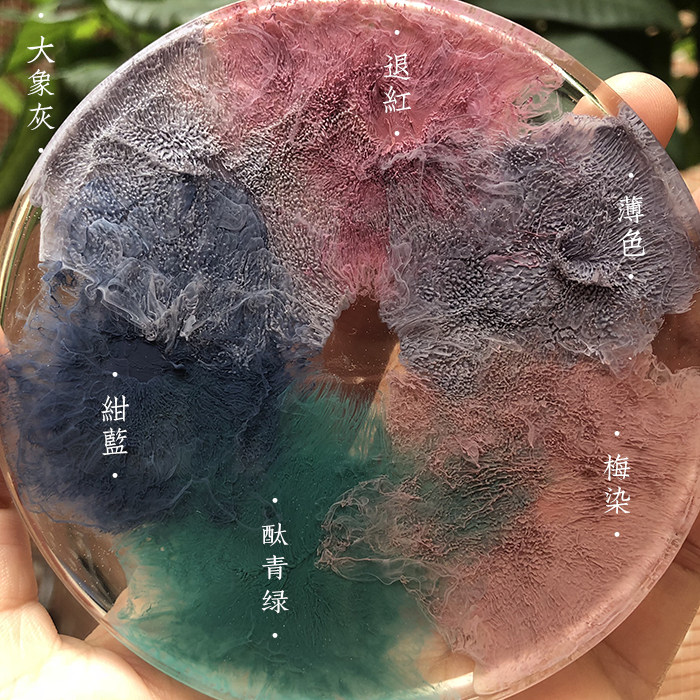

Artresin Brilliant Cloud Resin Art -Self -Tride Ink Rase Rasin Driping Glossal Bad Ink Douyin Quick Hand
Цена: 250-4 396руб. (¥11.8)
Артикул: 590087388455
Вес товара: ~0.7 кг. Указан усредненный вес, который может отличаться от фактического. Не включен в цену, оплачивается при получении.
Описание товараPHA+0KHQsNC80L7RgdGC0L7Rj9GC0LXQu9GM0L3Ri9C1INGH0LXRgNC90LjQu9CwINCd0L7QstCw0Y8g0YbQstC10YLQvtCy0LDRjyDRgdC40YHRgtC10LzQsCBNb3JhbmRpK9GG0LLQtdGC0L7QstCw0Y8g0YHQuNGB0YLQtdC80LAg0LzQsNC60LDRgNC+0L0uINCh0LLQtdC20LjQuSDQstC90LXRiNC90LjQuSDQstC40LQg0LzQvtC20LXRgiDQsdGL0YLRjCDQvdC10LfQsNCy0LjRgdC40LzRi9C8IDNEIEhhbG8sINC70YPRh9GI0LjQtSDRhtCy0LXRgtC+0LLRi9C1INGN0YTRhNC10LrRgtGLINGD0L/RgNCw0LLQu9C10L3QuNGPINC4INGC0YDQtdGF0LzQtdGA0L3Ri9C1INGN0YTRhNC10LrRgtGLINCx0LXQt9C+0L/QsNGB0L3Ri9C1INC4INGN0LrQvtC70L7Qs9C40YfQtdGB0LrQuCDRh9C40YHRgtGL0LUsINGB0YLQsNCx0LjQu9GM0L3Ri9C1INGG0LLQtdGC0LAsINC00LvQuNGC0LXQu9GM0L3QvtC1INC90LXQv9Cw0LTQuNGA0L7QstCw0L3QuNC1INC90LUg0LjRgdGH0LXQt9Cw0LXRgiDQsdC10Lcg0LjRgdGH0LXQt9C90L7QstC10L3QuNGPLjxpbWcgc3JjPSJodHRwczovL2ltZy5hbGljZG4uY29tL2ltZ2V4dHJhL2kzLzMyOTk1MzIzMjQvTzFDTjAxOUpTajRrMVQyUXkzdnAyUlpfISEzMjk5NTMyMzI0LmpwZyI+PGltZyBzcmM9Imh0dHBzOi8vaW1nLmFsaWNkbi5jb20vaW1nZXh0cmEvaTMvMzI5OTUzMjMyNC9PMUNOMDFLT0E4M0ExVDJReTNjQkx6bF8hITMyOTk1MzIzMjQuanBnIj48aW1nIHNyYz0iaHR0cHM6Ly9pbWcuYWxpY2RuLmNvbS9pbWdleHRyYS9pNC8zMjk5NTMyMzI0L08xQ04wMVJEbDNsNDFUMlF5M0lmZVNBXyEhMzI5OTUzMjMyNC5qcGciPjxpbWcgc3JjPSJodHRwczovL2ltZy5hbGljZG4uY29tL2ltZ2V4dHJhL2k0LzMyOTk1MzIzMjQvTzFDTjAxR2FzeWlHMVQyUXkxdzNaMlFfISEzMjk5NTMyMzI0LmpwZyI+PGltZyBzcmM9Imh0dHBzOi8vaW1nLmFsaWNkbi5jb20vaW1nZXh0cmEvaTEvMzI5OTUzMjMyNC9PMUNOMDFqZ1NITXYxVDJReHdNaWVqQl8hITMyOTk1MzIzMjQuanBnIj48aW1nIHNyYz0iaHR0cHM6Ly9pbWcuYWxpY2RuLmNvbS9pbWdleHRyYS9pMS8zMjk5NTMyMzI0L08xQ04wMTR4UmxWVTFUMlF5MmZkbkhPXyEhMzI5OTUzMjMyNC5qcGciPjxpbWcgc3JjPSJodHRwczovL2ltZy5hbGljZG4uY29tL2ltZ2V4dHJhL2kxLzMyOTk1MzIzMjQvTzFDTjAxaEhjZ25FMVQyUXk1SlJpSnBfISEzMjk5NTMyMzI0LmpwZyI+PGltZyBzcmM9Imh0dHBzOi8vaW1nLmFsaWNkbi5jb20vaW1nZXh0cmEvaTQvMzI5OTUzMjMyNC9PMUNOMDFuZDUzRUoxVDJReTFyYjJPMF8hITMyOTk1MzIzMjQuanBnIj48aW1nIHNyYz0iaHR0cHM6Ly9pbWcuYWxpY2RuLmNvbS9pbWdleHRyYS9pMS8zMjk5NTMyMzI0L08xQ04wMWxqUGRvODFUMlF5M0lIUGpMXyEhMzI5OTUzMjMyNC5qcGciPjwvcD4=
Продавец:广州道泽
Рейтинг:

Всего отзывов:0
Положительных:0
Выберите вариацию / цвет
Добавить в корзину
- Информация о товаре
- Фотографии
| Цвет: | Комплект, 18 цветов, Слон Серый, Дымка синяя, Зеленый бамбук, Коралловый порошок, Розовый порошок, Равиолин, Абрикос, Тонкий цвет, Руж, Глициния, Водяной синий, Красный, Мейран, Вишня, Зеленый, Серый, Молоко желтое, 酞 酞 酞 |
Самостоятельные чернила Новая цветовая система Morandi+цветовая система макарон. Свежий внешний вид может быть независимым 3D Halo, лучшие цветовые эффекты управления и трехмерные эффекты безопасные и экологически чистые, стабильные цвета, длительное непадирование не исчезает без исчезновения.